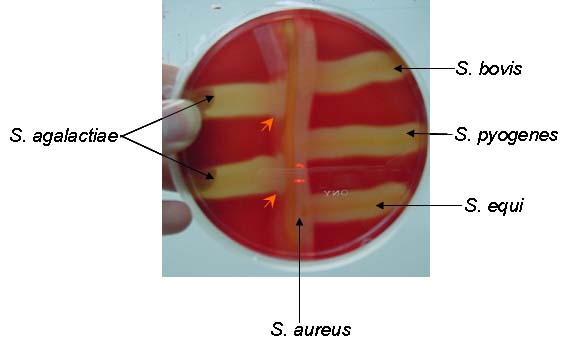

C.A.M.P. Test
The CAMP test was created to distinguish the species Streptococcus agalactiae from other species of beta-hemolytic Streptococcus, particularly Group D Streptococci. This test relies on the fact that most S. agalactiae strains produce a diffusible, extracellular compound called the CAMP substance, that will, in conjunction with a specific beta-hemolysin of Staphylococcus aureus, cause an increased hemolytic effect on red blood cells in an agar medium. The result is an arrowhead affect where the two species meet on an agar plate.
Note the arrows pointing to the "arrowhead effect" as hemolysins from S. aureus interact with hemolysins from S. aureus to produced an enhanced zone of beta-hemolysis.